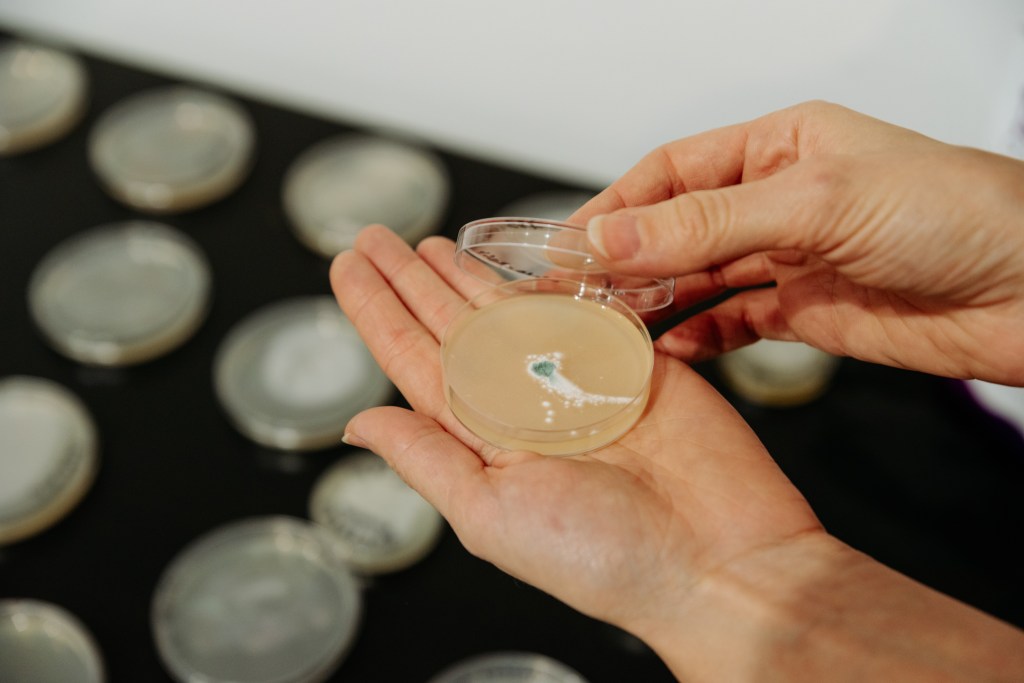

THE OUTDOOR BIOLAB
Radionice Outdoor BioLab (jul 2025) pružiće učesnicima priliku da se upuste u savremene umetničke prakse koje uključuju biomaterijale i žive organizme. Pod vođstvom iskusnih biotehničara, naučnika, umetnika i dizajnera, radionice će omogućiti praktično iskustvo u radu sa biomedijima, nudeći uvid u laboratorijske protokole, dok istovremeno otkrivaju interesantne i praktične aspekte nauke.
U okviru projekta Bio Awaking izradili smo dokument „Razvijanje praksi zasnovanih na živim sistemima i uspostavljanje bioart laboratorija: smernice i perspektive iz prakse.“ Kompletan dokument na engleskom jeziku možete preuzeti u nastavku:

Program Outdoor BioLab
Outdoor BioLab biće postavljen od 4. do 13. jula 2025. godine, na Pecka Outdoor Festivalu u Mrkonjić Gradu, Bosna i Hercegovina. Tokom ovog perioda, radionice će voditi iskusni biotehničari, naučnici, umetnici i kulturni radnici.
Pod otvorenim nebom i u duhu Pecka Outdoor Festivala, posetioci će imati priliku da istraže DIY bio umetničke metode i učestvuju u iskustvima koja spajaju nauku i umetnost. Program nudi uvid u savremene umetničke prakse koje uključuju istraživanje i rad sa biomaterijalima i živim organizmima iz prirodne sredine.

PROGRAM Outdoor BioLab
4. jul 2025. – 13. jul 2025.
Pecka Outdoor Festival
Gornja Pecka 158, Mrkonjić Grad, Bosna i Hercegovina
Mikrofotografski safari – Lov na vodene medvediće
Radionica koju vode Gjino Šutić i Paula Garbin, Univerzalni istraživački institut – UR Institut
SUBOTA i NEDJELJA, 5-6. jul
Trajanje radionice: 30 min
Uzrasna grupa: deca, 5-14 (nije striktno ograničeno)
Radionica za decu koja uvodi svet mikroskopije kroz igru i praktično istraživanje. Učesnici će sakupiti sopstvene uzorke iz prirode, posmatrati ih pod mikroskopom i otkriti nevidljive oblike života kao što su vodeni medvedi (tardigradi). Svi zainteresovani moći će takođe da pokušaju da ilustruju prirodu kako bi zabeležili svoja zapažanja. Radionica podstiče radoznalost, naučno razmišljanje i pažljivo posmatranje prirode.








Uradi sam – Baterije od blata
Radionica koju vode Gjino Šutić i Paula Garbin, Univerzalni istraživački institut – UR Institut
SUBOTA i NEDJELJA, 5-6. jul
Trajanje radionice: 30 min
Uzrasna grupa: omladino, 15-30 (nije striktno ograničeno)
Radionica za omladinu koja uvodi učesnike u svet bioelektrohemije i obnovljivih izvora energije. Kroz praktičan rad, učesnici će naučiti kako da naprave DIY punjivu bateriju koja koristi organski otpad za generisanje električne energije i kako ova tehnologija može da se primeni u istraživanjima zaštite životne sredine i industriji kao biosenzor za detekciju zagađenja.
Radionica je zasnovana na inovativnom sistemu baterije i biosenzora razvijenom u UR Institutu.




O MENTORIMA
Gjino Šutić (HR) MSc.Med.Chem. Biotehnolog, inovator, edukator, novi medijski umetnik, producent, menadžer projekata i programa. Direktor Univerzalnog istraživačkog instituta (UR Institut) HR (2013-). Direktor Gen0 Industries d.o.o. za istraživanje i razvoj inovativnih tehnologija, HR (2014-). Predsednik Udruženja inovatora Dubrovačko-neretvanske županije, HR (2020-). Od 2012. godine aktivan kao multidisciplinarni istraživač i internacionalno nagrađivani developer inovacija specijalizovan u oblasti biotehnologije (sa fokusom na visoko eksperimentalnu, ekološku, medicinsku i industrijsku biotehnologiju), novih medijskih umetnosti (posebno biološke umetnosti i hibridne umetnosti povezane sa naukom i tehnologijom), novih oblasti nauke i tehnologije (medicinska hemija, biomehatronika/bioelektronika, biosemantika), komunikaciju nauke i popularizaciju STEAM-a kroz građansko istraživanje i eksperimentalnu praksu. Ima širok portfolio internacionalno priznatih projekata podržanih od strane Evropske komisije kroz programe kao što su Horizon, Creative Europe, Erasmus+, ESF i slični.
Paula Garbin (HR) Ima diplomu iz oblasti Ekoloških nauka sa Univerziteta Lancaster, UK. Trenutno je na master studijama na Univerzitetu u Bolonji, gde istražuje Menadžment prirode – Globalnu ekologiju promena i Ciljeve održivog razvoja. Njena teza se fokusira na istraživanje uticaja peletizovanog đubriva od ovčije vune na rast mediteranskih biljaka. Neke od njenih ključnih oblasti interesa su uticaj otpada na životnu sredinu, zaštita mora, zagađenje plastikom i opšte očuvanje prirode. Prethodno je radila u Institutu za istraživanje mora i obale u Dubrovniku na projektu koji se bavio novootkrivenim vrstama meduza i volontirala na meteorološkoj stanici Hazelrigg pri Univerzitetu Lancaster.

Papir koji raste
Radionica koju vodi Valentina Knežević, viša asistentkinja na Prirodno-matematičkom fakultetu, u saradnji sa Studentkom organizacijom ispred Fakulteta prirodnih nauka i matematike u Banja Luci
SUBOTA, 5. jul
Trajanje radionice: 60 min
Uzrasna grupa: 8-15 godin
Radionica pod nazivom “Papir koji raste” osmišljena je kako bi decu podstakla na razumevanje reciklaže i ljubav prema prirodi kroz zabavan i kreativan proces. Uz pomoć studenata, deca će naučiti kako da naprave ručno pravljen papir u koji će biti usađeni biljni semenci, koje će kasnije moći da posade i neguju kod kuće.
“Papir koji raste” je kreativna i edukativna radionica zasnovana na prirodnim naukama, namenjena deci uzrasta od 8 do 15 godina. Tokom radionice, učesnici će imati priliku da recikliraju stari papir i transformišu ga u novi, ručno pravljen papir obogaćen biljnim semenom. Kada papir bude napravljen i osušen, može se posaditi u zemlju, iz kojeg će narasti različite vrste biljaka.
Deca će proći kroz svaki korak procesa: od seckanja i potapanja starog papira, do oblikovanja i ukrašavanja novog papira semenkama. Radionica je prilagođena uzrastu i vodiće je tim studenata uz podršku mentora.





O MENTORIMA
Studentka organizacija Prirodno-matematičkog fakulteta Univerziteta u Banjaluci okuplja studente različitih oblasti prirodnih nauka. Organizacija već nekoliko godina učestvuje u Pecka Outdoor festivalu, gde realizuje interaktivne radionice i edukativne aktivnosti za decu i omladinu. Kroz različite projekte i inicijative, članovi organizacije aktivno promovišu nauku. Učešće na festivalu vide kao odličnu priliku da kombinuju edukaciju i zabavu, te inspirišu mlade da razmišljaju ekološki.
Ove godine, učesnici festivala su studenti Marija Manojlović, Nina Kutić, Anastazija Zrnić, Marko Kalaba, i predsednica Studentke organizacije, Valentina Knežević, uz mentorstvo Dragice Delić, više asistentkinje na Fakultetu.

Od niti do dela – Izrada tapiserija od čiste vune
Radionica koju vode Jelena Vučić i Aleksandra Trninić, umetnice
SUBOTA, 5. Jul
Trajanje radionice: 60 min
Uzrasna grupa: od 7 godina na dalje
U okviru pratećeg programa 6. Pecka Outdoor festivala, biće održana radionica izrade tapiserija za decu i mlade, koja učesnicima pruža priliku da se upoznaju sa vunom i nauče, kroz zabavan i kreativan proces, kako nastaju tepisi – od niti do gotovog dela. Učesnici će biti uputeni na osnove ovog prirodnog materijala, osnove tkanja i proces izrade tapiserija – tradicije koja je duboko ukorenjena u lokalnoj kulturnoj baštini. Takođe, upoznaće moderan alat koji se koristi u ovom umetničkom zanatu – tufing gun, koji omogućava brzo i ekspresivno stvaranje dekorativnih tepiha.
Radionica traje do tri sata i obuhvatiće:
- Kratko uvodno predavanje o tradicionalnom tkanju i izradi tapiserija,
- Demonstraciju upotrebe tufing guna,
- Praktičan segment u kojem će učesnici, uz pomoć mentora, kreirati svoje mini tepihe.
Rad se vrši u malim rotirajućim grupama, što podstiče saradnju i međusobnu podršku. Na kraju, svi učesnici će doprineti zajedničkom stvaranju velike kolektivne tapiserije na zajedničkom okviru. Ova radionica pruža deci priliku da razviju svoj umetnički osećaj, steknu praktično iskustvo sa alatima i nauče kako da rade u timu. A najbolji deo je što će na kraju poneti jedinstveni komad svog stvaralaštva!






Prirodna paleta – Radionica slikanja sa prirodnim pigmentima
Radionice vode: Jelena Vučić i Aleksandra Trninić, umetnice
SUBOTA, 5. Jul
Trajanje radionice: 60 min
Uzrasna grupa: od 7 godina na dalje
U okviru pratećeg programa 6. Pecka Outdoor festivala, biće održana kreativna slikarska radionica za decu – ali na potpuno drugačiji način: deca će slikati koristeći boje koje će same napraviti iz prirode!
Kroz igru, istraživanje i praktično učenje, deca će napraviti svoje boje koristeći razne prirodne i biljne materijale kao što su kurkuma, cvekla, crvena paprika, trava, bobice i druge biljke koje pronađu u okolini. Na taj način će naučiti kako se boje izvode iz prirode i kako su ljudi nekada pravili pigmente pre nego što su industrijske boje postale dostupne.
Radionica traje do dva sata i uključuje: prikupljanje i pripremu materijala, pravljenje jednostavnih prirodnih pigmenata sličnih akvarelu i njihovu upotrebu za slikanje na papiru.
Ova radionica je prilika za decu da pokrenu svoju maštu, povežu se s prirodom na nov način i otkriju kako umetnost može biti duboko povezana s okolinom. Sve što koriste – napraviće same, a sve što naslikaju – biće potpuno jedinstveno! Cilj je da učesnici razviju nove veštine, kreativnost, osećaj za materijale oko sebe i ljubav prema umetnosti i prirodi kroz igru i stvaranje.





O MENTORKAMA
Jelena Vučić (BH) je vizuelna umetnica iz Banjaluke čija praksa obuhvata slikarstvo, video umetnost, performans, animaciju i instalaciju. Završila je osnovne i master studije na Akademiji umetnosti Univerziteta u Banjaluci, gde trenutno radi kao asistent. Njena dela su predstavljena na značajnim izložbama i savremenim umetničkim festivalima u Srbiji, Bosni i Hercegovini i inostranstvu – uključujući Beograd, Veneciju, Užice i Skokie. Dobitnica je brojnih nagrada, među kojima se izdvajaju Zlatna značka za studenta generacije i nagrada Muzeja savremene umetnosti Republike Srpske. Kroz svoje radove, Jelena istražuje granice između vidljivog i nevidljivog, ljudskog i božanskog.
Aleksandra Trninić (BH), rođena u Tesliću, umetnica je čije slikarstvo nosi snažnu narativnu i društvenu poruku. Nakon završetka studija slikarstva na Akademiji umetnosti u Banjaluci, razvila je bogat portfelj izložbi kroz brojne samostalne i grupne izložbe širom Bosne i Hercegovine i Srbije. Dobila je priznanja za svoj rad u različitim medijima – od crtanja i mozaika do ikonopisanja. Aleksandra je aktivna kao edukatorka na brojnim umetničkim radionicama za decu i mlade, kao i u okviru kulturnih festivala, kampova i obrazovnih programa. Njena praksa je zasnovana na umetnosti kao sredstvu povezivanja, razumevanja, transformacije i osnaživanja zajednice.

Kružni pogled
Radionicu vodi: Phyllis Januel, studentkinja dizajna
SUBOTA, 12. jul
Trajanje radionice: 60 minuta
Uzrast: Za sve starije od 7 godina
Radionica će se održati na engleskom jeziku
Kružna struktura u potpunosti izgrađena od bala slame, osmišljena kao prostor za odmor, kontemplaciju i druženje. Ovaj prostor poziva posetioce da sednu, legnu, posmatraju nebo, razgovaraju ili jednostavno naprave pauzu od festivalskih dešavanja. Kružni oblik podstiče razmenu i susrete. U zidove su integrisani otvori koji propuštaju svetlost, oblikuju kadrove pejzaža i bude radoznalost. Ovi „otvoreni prostori” podstiču nas da gledamo drugačije, da zamišljamo ono što se nalazi s druge strane — poput prozora u scenografiju koju treba dopuniti maštom.
Radionica takođe istražuje održive i privremene tehnike gradnje. Osnova strukture biće prethodno pripremljena od bala slame, a učesnici će potom biti pozvani da je premažu zemljanom mešavinom — prirodnim spojem gline, vode i slame. Kroz ovaj zajednički čin, svaki učesnik ima priliku da ostavi svoj trag — ističući otvore, kreirajući teksture površine ili osmišljavajući uzorke. Tokom vremena, ovako ko-kreirana struktura prerasta u vibrantan, živi prostor koji se razvija zajedno sa zajednicom.
Prethodno iskustvo nije potrebno — dovoljni su radoznalost, kreativnost i spremnost da se ruke uprljaju.





O MENTORKI
Phyllis Januel (FR) potiče iz regiona Drôme/Ardèche, a njena duboka povezanost sa ruralnim okruženjem oblikovala je dugogodišnje interesovanje za svet poljoprivrede. Godine 2024. stekla je Nacionalnu diplomu iz umetnosti (DNA) u oblasti dizajna na ESADTPM. Njena završna teza fokusirala se na životni ciklus otpada od jabuka nastalog u okviru poljoprivredne proizvodnje na imanju Domaine de Gabalie u Lozèreu, gde se proizvode vino i sok od jabuke. Istraživala je načine ponovne upotrebe tog otpada s ciljem isticanja rada lokalnog proizvođača. Trenutno pohađa master studije iz dizajna predmeta na ENSAD-u u Limožu (Francuska). Njeno istraživanje fokusirano je na koncept vrta — ne samo kao prostora za proizvodnju hrane, već i kao mesta nege osoba sa invaliditetom. Njena interesovanja nalaze se na preseku ekološke svesti, ponovne upotrebe otpada i bogatstva ruralnog sveta.

Inteligentan uvod u biodizajn
Radionicu vodi: Maja Halilović, biodesignerka i inovatorka
SUBOTA, 12. jul
Trajanje radionice: otprilike 60 min
Uzrasna grupa: 15+
Prvi dan radionice započeće predavanjem koje će učesnicima predstaviti teorijske i filozofske osnove biodesigna. Biodesign se ne posmatra samo kao održivi dizajn, već kao duboko promišljen pristup koji integriše žive organizme, mikroorganizme i organske procese u sam čin stvaranja. Kroz tematske module, učesnici će istraživati razlike između pojmova kao što su biodesign, biofabrika, biophilic design i bio-utopija, uz kratak istorijski pregled – od ranih eksperimenata do današnjih spekulativnih i regenerativnih praksi. Posebna pažnja biće posvećena mikroorganizmima kao “koautorima” dizajna – bakterijama, algama i gljivama – kao aktivnim agentima u stvaranju budućih materijala. Biologija se posmatra kao kreativna platforma, a dizajn kao most između tehnologije i prirode.
Maja Halilović predstaviće svoje originalne biomaterijale razvijene od ljuski jaja, SCOBY kultura, kafe, micelijuma i drugih bio-izvora, sa naglaskom na radove u vezi sa bio-kožom, čvrstim micelijumskim strukturama i bio-penama. Učesnici će imati priliku da vide i analiziraju uzorke materijala, skice i prototipove. Predavanje će se završiti diskusijom koja istražuje kako filozofska, tako i praktična pitanja: Da li priroda može biti dizajnirana? Da li je biodesign novi oblik aktivizma? I koji je budućnost materijala u eri klimatskih promena?





Biomaterijali u praksi
Radionicu vodi: Maja Halilović, biodesignerka i inovatorka
NEDELJA 13. Jul
Trajanje radionice: otprilike 60 min
Uzrasna grupa: 15+
Drugi dan radionica je u potpunosti posvećen praktičnom radu i eksperimentisanju. Učesnici će raditi u malim grupama, upoznati se sa osnovnim principima laboratorije za biomaterijale, i – pod stručnim nadzorom – razvijati svoje uzorke biomaterijala. Rad će se bazirati na jednostavnim i dostupnim sastojcima: biološkom otpadu iz kuhinje (npr. ljuske jaja, talog kafe), prirodnim pigmentima (kao što su spirulina, kurkuma, aktivni ugalj) i biorazgradivim, netoksičnim vezivnim agentima. Proces uključuje mešanje sastojaka, oblikovanje i modeliranje materijala, sušenje, eksperimentisanje sa teksturama i bojama, kao i dokumentovanje rezultata u takozvanom “laboratorijskom dnevniku”. Svaka grupa beleži proporcije, zapažanja i faze procesa putem teksta i fotografija.
Završni deo radionice fokusiraće se na predstavljanje rezultata, kolektivnu refleksiju i zamišljanje budućnosti biomaterijala – kako bi mogli izgledati, gde bi mogli biti primenjeni i da li bi mogli zameniti plastiku, tekstil ili građevinske materijale.
U paraleli, biće organizovana i „materijalna meditacija“ – taktilna mini-izložba uzoraka biomaterijala sa specifičnim mirisima i teksturama, uz ambijentalnu zvučnu podlogu. Cilj je stimulisati sva čula i prikazati biodesign kao senzornu i duboko povezanu iskustvo.




o mentorki
Maja Halilović (BH) je biodesignerka sa devetogodišnjim iskustvom u radu sa živim organizmima poput SCOBY kultura i micelijuma, razvijajući inovativne biomaterijale od organskog otpada. Njeni radovi se nalaze na preseku nauke, dizajna i ekologije, pomerajući granice održivih materijala. Za svoje izume, kao što je Biocandle – biomaterijal od organskog otpada, osvojila je zlatnu nagradu od Korejskog zavoda za intelektualnu svojinu (KIPO) i KWIA, kao i bronzanu medalju na 75. IENA sajmu u Nirnbergu. Osvojila je prestižnu MADE IN BIH AWARD 2023 u pet kategorija. Od 2023. godine, članica je Udruženja inovatora Bosne i Hercegovine, doprinosi kroz mentorstvo, edukaciju i promociju biodesigna. Njeni projekti su predstavljeni u Londonu, Kelnu, Beogradu, Ljubljani i drugde. U 2025. godini, njen fokus je na razvoju proizvoda od biomaterijala—posebno Biocandle—i održivom dizajnu nameštaja, spajajući regenerativni dizajn, kružnu proizvodnju i ekološku svest.

Gaijine Sonične Transmisije
Radionicu vodi: Nastja Ambrožič, mentor, edukator, umetnica
SUBOTA, 12. jul
Trajanje radionice: max 120 min (na engleskom jeziku)
Uzrasna grupa: 18+ (nije strogo ograničeno)
Radionica će se održati na engleskom jeziku
Ispod šumskog tla, u brujanju micelijumskih niti i pulsiranju korena, Gaija govori. Ne rečima, već u statici, frekvencijama, u smetnjama koje talasaju kroz tlo i tišinu. Ovo nije koncert. To je zajedništvo – sa gljivama, sa biljkama, sa bioelektričnim signalima. Sonicni ritual gde tehnologija sluša, umesto da naređuje. Ovdje se usklađujemo sa porukama koje nikada nismo naučili da čujemo – kroz praksu dubokog slušanja.Inspirisani fascinacijom kompozitora Džona Kejdža za pečurke i njegovim verovanjima u učenju od prirode, ova radionica poziva učesnike da slušaju žive organizme i pretvore njihove bioelektrične signale u žive zvučne pejzaže.
Prototipaćemo i koristiti DIY bio-podatkovni sintetizator koji “prevodi” bioelektrične impulse u zvuk. Učesnici će istraživati kako tehnologija može postati alat za percepciju i stvaranje u saradnji sa prirodom. Radionica naglašava ekofeministički pristup koji podstiče poštovanje više-od-ljudskih životnih formi i simbiotskih odnosa.




O MENTORKI
Nastja Ambrožič (SI) je mentor, edukator i nova prisutnost u oblasti intermedijalne umetnosti, istražujući povezanost umetnosti, biologije, ekologije i DIY tehnologije. U svojoj praksi često sarađuje sa živim organizmima – gljivama, biljkama i mikroorganizmima. Takođe razvija i vodi interaktivne, immersivne radionice za decu, mlade i odrasle. Njeno istraživanje zasnovano je na višeznačnom razumevanju sveta, više-od-ljudskih entiteta. Stvara formate koji podstiču kritičko razmišljanje, radoznalost i otvorenost za nepoznato – kroz igru, eksperimente i susrete sa neobičnim. Njeni projekti spajaju naučne metode i umetničke pristupe u istraživanju i su-stvaranju sa živim sistemima.

Živi sistemi kroz umetnost
Radionicu vodi: Kristijan Tkalec, šef BioTehna laboratorije na Kersnikova institutu
SUBOTA, 12. jul
Trajanje radionice: 120 min
Uzrasna grupa: 18+ (nije strogo ograničeno)
Ova radionica će upoznati učesnike sa različitim pristupima koje umetnici koriste da integrišu žive sisteme u svoju umetničku praksu. Sesija će početi prikazivanjem zanimljivih savremenih istraživačkih umetničkih projekata, sa naglaskom na kolaborativne procese između umetnika i naučnika. Inspirisani nekim od umetničkih projekata, zatim ćemo se dublje upustiti u svet mikroorganizama kroz praktično iskustvo, pokrivajući njihove osnovne funkcije, tehnike kultivacije i osnovnu (DIY) laboratorijsku opremu.







O MENTORU
Kristijan Tkalec (SI) je biotehničar i od 2013. godine radi kao stručni šef BioTehna – Laboratorije za umetničko istraživanje živih sistema i glavni mentor istraživačkog obrazovnog programa na Kersnikova institutu. Sproveo je i olakšao širok spektar projekata, radionica i eksperimenata u oblasti DIYbio, biotehnologije i biohemije, i sarađivao sa brojnim umetnicima, DIYbio inicijativama i zajednicama. Su-koncepirao je i vodio brojne radionice za različite publike na Kersnikova institutu i su-razvijao seriju radionica za edukatore i nastavnike u saradnji sa Nacionalnim institutom za obrazovanje Slovenije.

Mikrosvet plesni
Radionicu vodi: Milica Rukavina, učesnica Biostart programa, Reaktor
NEDELJA, 13. jul
Trajanje radionice: 60 min
Uzrasna grupa: 8-14 godina
Edukativna radionica „Mikrosvet plesni“ je osmišljena da decu upozna sa osnovama mikrobiologije kroz interaktivno istraživanje njihove prirodne sredine, sa posebnim fokusom na plesni – sveprisutne mikroorganizme koji često ostaju neprimećeni.
Sesija počinje sa kratkom, informativnom prezentacijom (do 20 minuta) koja pokriva osnovne vrste plesni, njihove ekološke uloge i načine reprodukcije. Nakon uvoda, učesnici će učestvovati u vođenom terenskom radu, prikupljajući uzorke iz svog okruženja u potrazi za prirodno prisutnim plesnima. U zavisnosti od tehničkih uslova, prikupljeni uzorci biće pregledani pomoću mikroskopa ili lupe, što će deci omogućiti direktan uvid u mikrobni svet.
Kao uspomenu, svaki učesnik će dobiti tri petrijeve zdjelice sa hranljivim agarem, što im omogućava da pokušaju samostalno kultivisanje plesni kod kuće i posmatraju njihov razvoj tokom narednih dana.






O MENTORKI
Milica Rukavina (RS) je iz Subotice i ima 25 godina. Studentkinja je na Prirodno-matematičkom fakultetu Univerziteta u Novom Sadu, na smeru biologija. Njena strast prema mikrobiologiji datira još iz srednje škole, kada je učestvovala na raznim takmičenjima iz biologije. Tokom četvrte godine studija, imala je priliku da nauku sagleda iz drugačije perspektive kroz rad na bioart projektu. Perspektive umetnika tog vremena otvorile su joj nove mogućnosti da istražuje nauku koju studira, kao i njenu blisku povezanost sa umetnošću. Motivisana radom mnogih umetnika i naučnika, rado se pridružila projektu BioAwaking, koji je inspirisao nastanak njenog projekta pod nazivom „Kutija realnosti“.

OKTUGLI STO SA PROJEKTNIM UČESNICIMA
Moderatorka: Milica Rašković (RS)
Učesnici/-ce: Nastja Ambrožič (SI), Maja Halilović (BH), Phyllis Januel (FR), Mateja Marković i Milica Rukavina (RS)
NEDELJA, 13. jul
Okrugli sto sa učesnicima okuplja nove i etablirane praktičare koji deluju na preseku umetnosti, dizajna, nauke i tehnologije. Učesnici su: Maja Halilović (BH), biodizajnerka koja transformiše organski otpad u inovativne materijale; Phyllis Januel (FR), dizajnerka koja istražuje ruralnu održivost i prakse brige; Milica Rukavina (RS), biolog koji spaja mikrobiologiju i umetnički eksperiment; Mateja Marković (RS), umetnik novih medija koji istražuje bioetiku kroz istraživanja, intervjue i kritičku refleksiju o našem odnosu prema životu; i Nastja Ambrožič (SI), intermedijalna umetnica i edukatorka čija praksa spaja umetnost, ekologiju, biologiju i DIY tehnologiju. Diskusija otvara prostor za preispitivanje materijala, metoda i etike kreativne prakse u post-disciplinarnom svetu.







MOBILNA LABORATORIJA
Radionice BioTehna mobilne laboratorije / Mobilni lab (septembar 2024. i jun 2025.) pružiće učesnicima priliku da se uključe u savremene umetničke prakse koje uključuju biomaterijale i žive organizme. Pod vođstvom iskusnih biotehnologa i naučnika, radionice će omogućiti praktično iskustvo u radu sa biomedijima, pružajući uvid u laboratorijske protokole i otkrivajući zanimljivu i praktičnu stranu nauke.
Prijave za radionice Mobilne laboratorije podnose se putem onlajn formulara koji se može pronaći na sledećem linku – OVDE.
Možete se prijaviti za više radionica.
Prijave su otvorene od 9. septembra 2024. godine.
Rok za prijavu produžen je do 19. septembra 2024. godine.
Više informacija o radionicama Mobilne laboratorije možete pronaći u PROGRAMU ispod.

O BioTehna Mobilnoj Laboratoriji
Kako bi se prilagodili specifičnim biotehničkim zahtevima i radnim uslovima potrebnim za pripremu i prezentaciju umetničkih dela koja uključuju delikatne biomedije u umetničkim prostorima koji ne mogu ispuniti takve uslove, Institut Kersnikova (Ljubljana, SI) razvio je Mobilnu laboratoriju. Ovaj mobilni, modularni dodatak našoj fizičkoj Laboratoriji za veštački život pruža umetnicima i istraživačima koji rade sa biomedijima kontrolisano okruženje za razvoj, eksperimentisanje i produkciju njihovih umetničkih projekata. BioTehna Mobilna laboratorija je savremena, laboratorija nivoa 2, opremljena naučnom opremom, osmišljena da ponudi eksperimentalni i produkcioni prostor na licu mesta za umetnike koji rade sa biomedijima. Mobilna laboratorija može se koristiti i za edukativne radionice i druge praktične aktivnosti koje povezuju naučne i umetničke metodologije.
Program BioTehna Mobilne Laboratorije
BioTehna Mobilna laboratorija biće postavljena na 2 nedelje (20. septembar – 4. oktobar 2024.) tokom festivala Kaleidoskop kulture u ateljeu SKUP, gde će se održavati radionice pod vođstvom iskusnih biotehnologa i naučnika iz Instituta Kersnikova i UR Instituta. Uz prezentaciju mogućnosti Mobilne laboratorije, uvod u rad BioLab-a i druge radionice, učesnicima i posetiocima pružićemo uvid u savremene umetničke prakse koje uključuju istraživanje i rad sa biomaterijalima i živim organizmima.

PROGRAM BioTehna Mobilne Laboratorije
21. Septembar – 4. Oktobar 2024.
SKUP, Kreativni Distrikt, Novi Sad, Srbija
Bulevar despota Stefana 5.
Uvod u rad BioLab-a (DIY i profesionalne postavke)
Workshop led by Kristijan Tkalec (Kersnikova Institute) and Gjino Šutić (Universal Research Institute – UR Institute)
Subota, 21. septembar
16:00-17:00 i 18:00-19:00
Subota, 28. septembar
17:00-18:00
Trajanje radionice: 60 minuta
Koje su razlike između biološkog inženjeringa i avangardne umetnosti? Postoje li, ili je moguće spojiti ih u kreativni lonac beskrajnih mogućnosti?
Pridružite nam se i otkrijte tokom interaktivnog vođenja kroz svet bioloških umetnosti i njegove kolevke – biolaboratorije.
Tokom interaktivnog vođenja, učesnici će dobiti uvid u najsavremenije biotehnološke laboratorije koje se koriste za istraživanje na spoju nauke i umetnosti, upoznaće se sa komercijalnom opremom koja se koristi u radu, kao i sa njenim Do-It-Yourself (DIY) verzijama. Istražićemo laboratorijsko okruženje i primere tehnički naprednih BioArt dela proizvedenih u BiroTehni/Institutu Kersnikova (SI) i UR Institutu (HR). Interaktivno iskustvo zaokružićemo praktičnim uvodom u tehnike molekularne biologije koje se najčešće koriste u genetičkoj analizi i modifikaciji.









Gajenje života: Praktično iskustvo u kultivaciji ćelija
Radionicu vodi Kristijan Tkalec (Institut Kersnikova)
Ponedeljak, 23. septembar
11:00 – 11:40; 12:00 – 12:40 i 17:00 – 17:40; 18:00 – 18:40h
Utorak, 24. septembar
11:00 – 11:40; 12:00 – 12:40 and 17:00 – 17:40; 18:00 – 18:40h
Trajanje radionice: 40 minuta
U ovoj praktičnoj radionici, učesnici će steći sveobuhvatno razumevanje rukovanja i rada sa ćelijama sisara. Pokrićemo sve, od osnovne opreme i laboratorijskih uslova, do suptilnosti aseptičke tehnike, sejanja ćelija, postavljanja kulture, vitalnosti ćelija, rasta, održavanja i rešavanja problema.Pored praktičnih aspekata, bavićemo se osnovnim principima kulture ćelija, uključujući terminologiju, osnovnu biologiju ćelija i zahteve za rast. Takođe, istražićemo potencijalne primene biomedija u umetničkom kontekstu.









Uvod u in vitro tehnike (ćelije i tkiva kao biomaterijali) za umetnost i dizajn
Radionicu vode Gjino Šutić (Universal Research Institute – UR Institute) i Margherita Pevere
Četvrtak, 26. septembar
18:00 – 21:00h
Trajanje rdionice: 180 minuta
Gjino Šutić (biotehnolog i veteran BioArta) i Margherita Pevere (umetnica i istraživač) pružiće praktičnu i teorijsku radionicu o in vitro tehnikama za žive ćelije i tkiva u bioartu i DIY (Do-It-Yourself) bio. Učesnici će naučiti kako da izoluju žive ćelije iz tkiva sisara i kultivišu ih – kako bi eksperimentiisali sa proizvodnjom tkiva i biomaterijala, ili istraživali inženjering organa, biorobotiku i prototipizaciju.Radionica će se fokusirati na ‘gerilsku’ i ‘hakovanja’ tehniku, s ciljem da se istaknu principi laboratorijskog rada i podstakne svesno razumevanje biotehnologije u kontekstu savremenih izazova. Nakon radionice, učesnici će biti pozvani da dizajniraju sopstvene koncepte i izlože ih kao postere u galeriji.








Zdravlje životne sredine – tlo (DIY nauka / građanska nauka)
Radionicu vode Gjino Šutić i Filip Grgurević (Universal Research Institute – UR Institute)
Petak, 27. septembar
18:00 – 19:00h
Trajanje radionice: 60 minuta
U ovoj praktičnoj radionici, učesnici će steći uvid u nevidljive misterije tla i parametre koji se odnose na njegovo zdravlje.
Kako možemo izvršiti hemijsku analizu tla koristeći svakodnevne kućne predmete?
Kako možemo analizirati mikrobni svet tla i učiniti nevidljive mikroorganizme tla vidljivim kod kuće?
Kako možemo poboljšati zdravlje tla?
Pridružite nam se i saznajte…
Radionica se zasniva na radnoj svesci “Zaronite u svet građanske nauke” koju su razvili autori radionice (ko-finansirano od strane Erasmus+ projekta Dive in).









OKRUGLI STO SA UMETNICIMA
Moderator: Sonja Jankov (RS);
Umetnici: Zoran Srdić Janežič (SI), Dr Margherita Pevere (IT/DE), Dr Karolina Żyniewicz (DE/PL), Adrienn Újházi (RS/HU);
Subota, 28. septembar
18:00 – 19:00h
Trajanje razgovora: 60 minuta
Okrugli sto sa umetnicima okuplja dinamičnu grupu kreatora koji rade na preseku umetnosti, nauke i tehnologije. Karolina Żyniewicz, umetnica, istraživač i edukatorka sa sedištem u Berlinu, poznata je po svom istraživačkom pristupu živim materijama i biotehnologiji u različitim kontekstima, pomerajući granice. Dr Margherita Pevere, umetnica i istraživač, izaziva društvene tabue kroz duboko razmatranje smrti, seksa i ranjivosti. Zoran Srdić Janežič, skulptor i intermedijalni umetnik iz Slovenije, inovira sa animatronikom i biotehnologijama, spajajući mehaničke i biološke elemente u svojim fascinantnim umetničkim delima. Adrienn Újházi, vizuelna umetnica, istražuje odnos između ljudi i prirode kroz različite medije, doprinoseći brojnim projektima i izložbama. Zajedno, ovi umetnici izazivaju razmišljanje, istražuju korišćenje biomaterijala kao medija i inspirišu dijalog na preseku umetnosti, nauke i tehnologije.









FunGArt – od izolacije i manipulacije do inspiracije i instalacije
Radionicu vodi Dr Milana Rakić (RS), mikolog i mikrobiolog
Sreda, 2. oktobar
18:00 – 20:00
Petak, 4. oktobar
18:00 – 20:00
Trajanje radionice: 120 minuta
Učesnici će izolovati i manipulisati kulturama gljiva, kao i plodištima gljiva, koristeći ih kao inspiraciju za stvaranje jedinstvenih umetničkih dela. Radionica uključuje instalaciju ovih kreacija, transformišući naučno istraživanje u umetnički izraz. FunGArt će pružiti praktično iskustvo koje redefiniše gljive kao alat za učenje i umetnički eksperimenat.














Inicijativa Bio StArt pruža učesnicima priliku da razvijaju svoje bio-umetničke projekte uz profesionalnu podršku umetnika i naučnika. Odabrani učesnici za Bio StArt program su: Jelena Komloš, Mateja Marković, Viktor Cvejić, Milica Rukavina, Vuk Mandušić, Sanja Rajić, Angelina Biskupljanin i Milica Krneta, koji su imali priliku da predstave svoje početne ideje i koncepte tokom izložbeBio Instalacija, održane kao deo festivala Kaleidoskop Kulture.
Najistaknutiji projekti biće prikazani na Outdoor Pecka Festivalu 2025. godine u Bosni i Hercegovini, kao i na narednoj ediciji art+science festivala u Beogradu.

Mentori radionica
GJINO ŠUTIĆ (HR) MSc.Med.Chem. Biotehničar, inovator, edukator, umetnik novih medija, producent, menadžer projekata i programa
- Direktor Universal Research Institute (UR Institute) HR (2013. – )
- Direktor Gen0 Industries d.o.o. za istraživanje i razvoj inovativnih tehnologija, HR (2014. -)
- Predsednik Udruženja inovatora Dubrovačko-neretvanske županije, HR (2020. -)
Od 2012. godine, aktivan kao multidisciplinarni istraživač i internacionalno nagrađivani developer inovacija specijalizovan za opštu biotehnologiju (sa fokusom na visoko ekspermentalne, ekološke, medicinske i industrijske oblasti), umetnost novih medija (posebno biološku umetnost i umetnost povezanu sa hibridnim naučno-tehničkim pristupima), nove oblasti nauke i tehnologije (medicinsku hemiju, biomehatroniku/bioelektroniku, biosemiotiku), naučnu komunikaciju i popularizaciju STEAM disciplina kroz građansku nauku i ekspermentalnu praksu. Ima širok portfolio međunarodno priznatih projekata podržanih od strane Evropske komisije kroz programe Horizon, Creative Europe, Erasmus+, ESF i slične.
FILIP GRGUREVIĆ (HR) ima master diplomu iz ekologije i zaštite životne sredine. Radi kao istraživač i koordinator obrazovnih aktivnosti za mlade na UR Institute. Njegovo istraživanje fokusira se na vodenu biologiju, mikrobiologiju i bioremedijaciju. Ima iskustva u radu na više EU projekata i saradnji sa istaknutim bioumetnicima kao podrška u naučno-umetničkim rezidencijama i srodnoj istraživačkoj produkciji.
KRISTIJAN TKALEC (SI) je biotehničar i od 2013. godine radi kao stručni voditelj BioTehna laboratorije i glavni mentor programa istraživačkog učenja na Kersnikova Institutu. Sproveo je i vodio širok spektar projekata, radionica i eksperimenata u oblasti DIYBio, biotehnologije, biologije i biohemije, sarađujući sa umetnicima, kao i sa DIYBio inicijativama i zajednicama poput Hackteria, Gaudilabs, Lab Easy, Hack-a-taq i drugih. Su-konceptualizovao je, implementirao i vodio brojne radionice za decu i mlade na Kersnikova Institutu, kao i su-razvio seriju radionica za edukatore i nastavnike u saradnji sa Nacionalnim institutom za obrazovanje.
DR. MARGHERITA PEVERE (IT/DE) je međunarodno priznati umetnik i istraživač koji deluje u oblasti biološke umetnosti i performansa sa prepoznatljivim visceralnim potpisom. Njena istraživanja kombinuju biotehnologiju, ekologiju, studije roda i smrti kako bi stvorila zapanjujuće instalacije i performanse koji prate današnju ekološku kompleksnost. Njeno delo je cvetajući vrt prepun genetski modifikovanih bakterija, ćelija, seksualnih hormona, mikrobiološkog biofilma, krvi, puževa, pepela i trulih ostataka. Su-osnivač je umetničke grupe Fronte Vacuo, a član je Finske bioart društva i Mreže za studije queer smrti. www.margheritapevere.com
DR MILANA RAKIĆ (RS) je mikolog iz Novog Sada, Srbija. Radi kao docent na Katedri za mikrobiologiju, Departman za biologiju i ekologiju, PMF, UNS, gde je član Mikološke laboratorije ProFungi. Njeno polje interesovanja i istraživanja obuhvata biologiju i ekologiju gljiva, diverzitet i zaštitu gljiva, biomonitoring, bioremedijaciju, biotehnologiju itd. Milana uživa u istraživanju oblasti umetnosti i nauke i do sada je učestvovala u nekoliko projekata u toj oblasti. Voli da deli svoju strast prema gljivama i prirodi sa drugima.
Podrška

Program Kreativna Evropa Evropske unije podržava aktivnosti koje promovišu kulturnu raznolikost i odgovaraju na potrebe i izazove u kulturnom i kreativnom sektoru. Glavni ciljevi programa su očuvanje konkurentnosti i ekonomskog potencijala kulturnog i kreativnog sektora, posebno audiovizuelnog sektora. Novi pristup programa doprineće oporavku ovih sektora podržavajući njihove napore ka većoj inkluzivnosti, digitalizaciji i održivosti u njihovom okruženju.
Projekat je sufinansiran od strane programa Kreativna Evropa Evropske unije, prema ugovoru o grantu broj 10112849. Stavovi i mišljenja izraženi u ovom projektu su isključivo stavovi autora i ne odražavaju nužno stavove Evropske unije ili Izvršne agencije za obrazovanje, audiovizuelnu i kulturnu politiku (EACEA). Evropska unija niti telo za finansiranje ne snose odgovornost za njih.
Finansirano od strane Evropske unije. Stavovi i mišljenja izražena su isključivo stavovi autora i ne odražavaju nužno stavove Evropske unije ili Izvršne agencije za obrazovanje, audiovizuelnu i kulturnu politiku (EACEA). Evropska unija niti EACEA ne snose odgovornost za njih. za njih.
